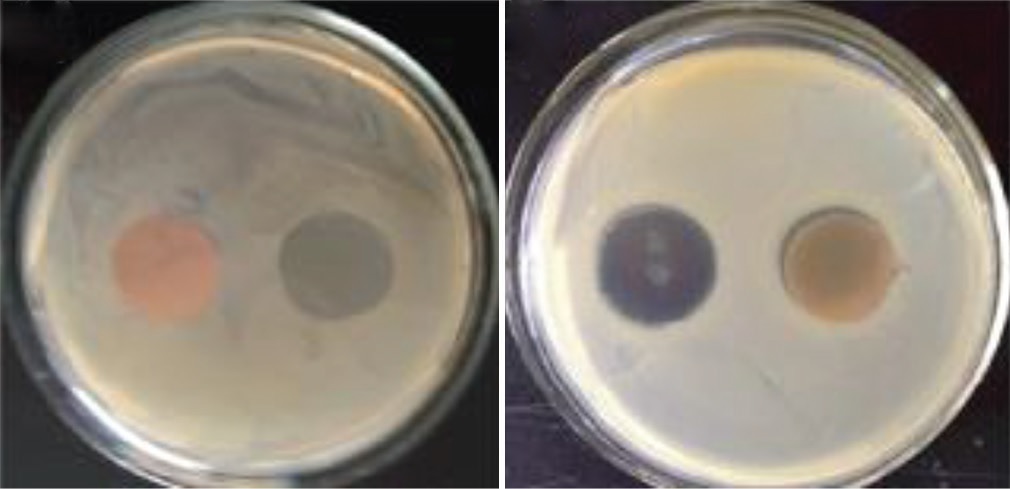
Article Image

Issue Details

May, 2022
Volume: 10, Issue: 2
📅 Published on: 05 May 2022
Articles in this Issue
2.
5 May, 2022
Research Article
Synthesis, Physico-chemical, Spectral, and Antibacterial Activity Studies of Ni(II), Mn(II), and Cu(II) Complexes of Schiff Base Ligand Containing Triazole moiety
Authors: Nayaz Ahmed*, Mohd Riaz, Suman Malik, Archana Singh
DOI: 10.22607/IJACS.2022.1002002 | Pages: 59-65
4.
5 May, 2022
Research Article
Dual Responsive Aminothiazole based Antibacterial Copolymeric Nanogels for Controlled Release of Anti-Human Immunodeficiency Virus Drug Zidovudine
Authors: Sana Eswaramma, Kummara Madhusudana Rao, G. Viswanatha Reddy, K. S. V. Krishna Rao*
DOI: 10.22607/IJACS.2022.1002004 | Pages: 70-78




